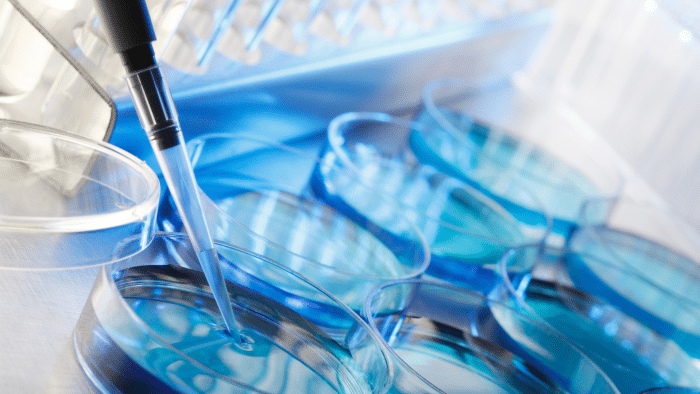

Did you know that Botox has been one of the top minimally invasive treatments in the world for over two decades? In 2022, it marked a significant milestone as healthcare professionals performed almost 9 million of these procedures that year. This impressive number reflects Botox’s rise from a therapeutic solution to a cosmetic trend.
Botox is a purified protein derived from botulinum toxin type A that temporarily relaxes facial muscles. Though it was first approved for medical conditions, Botox’s ability to erase years off one’s appearance has made it a vital procedure in aesthetic medicine.
In this article, we will delve into the fascinating history of Botox, exploring its medical origins and debunking common myths surrounding this treatment.
Key Takeaways
- Botox has evolved from a medical treatment for migraines, spasms, and excessive sweating to a popular cosmetic procedure for wrinkle reduction and facial rejuvenation.
- The transition of Botox from a medical marvel to a cosmetic craze has been influenced by cultural and societal factors, including celebrity endorsements, media coverage, and changing beauty standards.
- Addressing misconceptions and concerns about Botox is essential for individuals considering this treatment, as it provides evidence-based information on safety, efficacy, and potential side effects.
The Origins of Botox
Though Botox is synonymous with aesthetic and medical purposes in modern times, it boasts a surprising and fascinating history. Learning how Botox was discovered takes us back to the late 19th century. Its story began with Belgian bacteriologist Emile van Ermengem’s 1987 discovery of the botulinum toxin as the cause of botulism, a rare but severe illness that can lead to paralysis.
Fast forward to the 1920s, scientists at the University of California, San Francisco, began attempts to isolate the botulinum toxin for study. However, the first therapeutic use of botulinum toxin was in the 1970s when ophthalmologists used it to treat strabismus (crossed eyes). This application was a significant breakthrough, demonstrating the toxin’s potential for controlling muscle spasms.
Scientific Research and Clinical Trials
Throughout the mid-20th century, botulinum toxin was purified and studied for various medical applications. Dr. Edward J. Schantz played a pivotal role in its isolation and purification, leading to clinical trials in the 1970s that showcased the toxin’s effectiveness in treating conditions like muscle spasms and strabismus.
Double-blind, placebo-controlled studies, and open-label clinical trials proved that botulinum toxin could alleviate disorders associated with excessive muscle contraction or autonomic dysfunction when appropriate targets and doses were selected. These trials played a crucial role in establishing the therapeutic benefits of botulinum toxin type A.
Researchers documented its ability to alleviate symptoms, improve a patient’s quality of life, and, in some instances, offer a minimally invasive alternative to surgery. The data gathered from these trials formed the foundation for regulatory approval and paved the way for mainstream acceptance.
Approval by Regulatory Agencies and Mainstream Acceptance as a Medical Therapy
The relentless scientific research and clinical trials ended in a critical moment in 1989. The US Food and Drug Administration (FDA) approved botulinum toxin type A, marketed under Oculinum, for treating strabismus and blepharospasm. This regulatory approval marked a significant milestone, legitimizing its use as a safe and effective medical therapy.
The success of Oculinum did not go unnoticed. Allergan, a pharmaceutical company, recognized the broader potential of botulinum toxin type A and acquired the product in 1991. They renamed it Botox in 1992. ThoughBotox’s initial focus remained on therapeutic applications, a fortunate discovery developed during clinical trials.
Researchers observed the reduction of wrinkles around the injection sites, leading to the exploration of Botox’s cosmetic potential. This observation paved the way for its eventual use in aesthetic medicine, further pushing Botox into the mainstream.
The story of Botox is a notable example of how scientific curiosity, careful research, and clinical trials can transform a potentially deadly toxin into a life-changing medical treatment. From its humble beginnings to its widespread use today, Botox’s journey highlights the power of scientific exploration and its potential to improve human health and well-being.
The Transition of Botox

Botox is now synonymous with non-surgical facial rejuvenation. It can smooth out dynamic wrinkles, such as crow’s feet and forehead lines, and reshape facial contours, including slimming the jawline for a more aesthetically pleasing appearance. Its ability to relax muscle activity reduces wrinkles and allows for face contouring, contributing to a youthful look without invasive procedures.
Botox injections work by stopping the release of acetylcholine, a neurochemical that causes paralysis of the local muscles. This effect usually occurs within 24 hours to two weeks following the injection, resulting in a smoother and more youthful appearance.
How Dermatologists and Plastic Surgeons Popularized Botox Injections
Dermatologists and plastic surgeons played vital roles in popularizing Botox for aesthetic purposes. They recognized the growing interest in non-surgical cosmetic procedures and embraced Botox as a minimally invasive and effective option.
These specialists honed their injection techniques, targeting specific muscle groups to achieve desired aesthetic results. They also actively educated the public about Botox’s potential benefits, contributing to its increasing popularity.
The transition of Botox from a medical therapy to a popular aesthetic treatment highlights the ever-evolving landscape of cosmetic medicine. It’s a testament to the human desire to maintain a youthful appearance and the ongoing development of minimally invasive procedures to meet this demand.
The Cultural and Societal Impact of Botox
The rise of Botox as a cosmetic treatment has had a profound impact on culture and society, influencing everything from beauty standards to personal care routines. Celebrity endorsements have long been a powerful marketing tool, and their impact on the popularity of Botox is no exception.
High-profile figures in entertainment and media have normalized the use of Botox, making it more accessible and desirable to the public. Media coverage further fueled Botox’s cultural presence. Magazine articles, celebrity interviews, and even reality TV shows featuring cosmetic procedures all contributed to the normalization of Botox. It became a topic of conversation, sparking discussions about beauty standards and the desire for a youthful appearance.
Changing Beauty Standards and Antiaging Skincare Routines

The beauty industry is constantly evolving, and with the rising popularity of Botox, there has been a noticeable shift toward noninvasive cosmetic procedures. These treatments are seen as a less risky alternative to traditional surgery, offering convenience and minimal downtime, which appeals to the modern consumer’s lifestyle.
Botox has transcended its origins as a medical treatment, becoming a staple in antiaging skincare routines. Many people now know what Botox can do to your face, leading to its general acceptance as a routine procedure, not just among older individuals but also increasingly among younger demographics seeking to delay the signs of aging.
Factors like the growing number of qualified practitioners offering Botox injections, the relatively short downtime associated with the procedure, and the continued emphasis on youthful appearance contributed to its acceptance.
Addressing Misconceptions and Concerns About Botox
Botox has become a household term associated with wrinkle treatment and facial rejuvenation. However, its popularity comes with misconceptions and concerns that influence people’s understanding of these treatments. This section aims to clarify common issues and provide evidence-based information to help people make informed decisions.
Common Misconceptions about Botox
- Botox freezes your face: This myth is one of the top concerns many have about this treatment. They fear that using Botox can lead to a loss of facial expression. However, when administered by a licensed professional, Botox can target specific muscles to reduce wrinkles without compromising facial expressions.
- Botox is permanent and addictive: These injections do not create physical dependence. The effects wear off over time, and patients don’t seek more injections for purely physiological reasons. On the other hand, some individuals may be happy with the results and choose to continue treatment for aesthetic reasons.
- Botox is only for women: Men and women use this treatment for various purposes. In reality, the number of men receiving Botox, or “Brotox,” is on the rise as more men are seeking this treatment for cosmetic reasons as well as for medical conditions.
- Botox is only for wrinkles: While wrinkle reduction remains a widespread use, Botox has numerous therapeutic applications. It can treat chronic migraines, excessive sweating, and muscle spasticity.
Evidence-based Information on Safety and Efficacy
Botox has been extensively studied and FDA-approved for various therapeutic and cosmetic uses. Clinical trials have confirmed its safety and efficacy when administered by a qualified healthcare professional. Botox is a highly diluted substance, which further supports its safety profile. Only small quantities are used during injections, minimizing the risk of side effects.
Potential Side Effects of Botox Injections
The most common side effects of Botox injections are usually mild and occur at the injection site. These can include:
- Pain, swelling, or bruising
- Redness or bleeding
- Infection
- Headache or flu-like symptoms
- Nausea
- Muscle weakness or dizziness
- Difficulty swallowing
These side effects are typically quick and go away on their own. However, it’s vital to be aware of the severe side effects associated with Botox injections.
- Temporary drooping eyelid (ptosis): This can occur if Botox unintentionally migrates from the injection site to muscles around the eye. It’s usually temporary and resolves within a few weeks.
- Facial asymmetry: Uneven injection or muscle weakness can cause temporary facial asymmetry. A skilled injector can minimize this risk.
- Flu-like symptoms: Some people may encounter mild flu-like symptoms, such as fever or body aches, after Botox injections.
- Dry eyes: A patient receiving Botox near the eyes can temporarily weaken muscles responsible for tear production, leading to dry eyes.
- Eye irritation: This side effect can occur if Botox migrates near the eye.
- Difficulty swallowing or breathing: In rare cases, Botox can spread and affect muscles involved in swallowing or breathing. This reaction is a medical emergency and requires immediate attention.
- Allergic reaction: Although uncommon, allergic reactions like itching, swelling, or difficulty breathing can come from Botox treatments.
Making Informed Decisions About Botox Treatments
Considering Botox? Here’s a quick guide to ensure you make an informed decision:
- Know Your Goals: Be realistic about what Botox can achieve. Discuss desired outcomes with a doctor to see if they align with Botox’s capabilities. Explore alternative treatments if needed.
- Choose a Qualified Provider: Seek a board-certified dermatologist or plastic surgeon with experience in Botox injections and a good understanding of facial anatomy. Schedule a consultation to discuss your goals and any concerns.
- Understand the Risks and Benefits: Be aware of potential side effects and weigh them against the desired benefits. Discuss these with your doctor.
- Be Realistic About Expectations: Botox offers temporary results (3-4 months) and a subtle, natural-looking improvement. Discuss what “natural” means to you with your doctor.
- Post-Treatment Care: Follow your doctor’s instructions and report any concerning side effects promptly. Moreover, Botox is not a permanent treatment. The effects typically last 3-6 months, so plan for regular maintenance sessions. Consistency is vital to achieving and maintaining the desired results.
Conclusion
The evolution of Botox shows us how it started as a deadly toxin and then became an anti-aging champion. As it went beyond its therapeutic roots, Botox became a foundation in the cosmetic industry. This transition reflects advancements in dermatological science while emphasizing a broader cultural shift towards preventative and minimally invasive approaches to beauty.
Botox has redefined our approach to self-care and beauty, standing out as a symbol of innovation and adaptability while it reshapes our perceptions of aging. As research continues, Botox’s future holds promise for even broader therapeutic and aesthetic applications.
About: DoctorMedica stands as your reliable supplier for premium dermal fillers, viscosupplements, and a diverse range of medical essentials, including Botox. If you’re curious about “how Botox injection works,” our platform provides comprehensive insights into its mechanism of action, ensuring informed decisions for your practice and patient care. Take advantage of our promotions and free shipping for orders over $500, empowering you to offer your patients effective treatment with Botox injections while maximizing affordability through DoctorMedica.
FAQs
1. When did professionals start using Botox for cosmetic treatments?
Professionals began using Botox for cosmetic treatments after it received FDA approval for this purpose on April 15, 2002. This approval started its widespread use as a non-invasive option for aesthetic enhancements.
2. What is the right age to start Botox?
The recommended age to start Botox treatments typically falls in the late 20s to early 30s, when dynamic wrinkles become more apparent.
3. How long does Botox last?
Cosmetic Botox treatments last 3 to 6 months, but this duration can vary based on age, muscle activity, and the amount of product used.
References
American Society of Plastic Surgeons. 2022 ASPS Procedural Statistics Release. 2023. https://www.plasticsurgery.org/documents/News/Statistics/2022/plastic-surgery-statistics-report-2022.pdf
Whitcup SM. The History of botulinum Toxins in Medicine: A thousand year journey. In: Handbook of Experimental Pharmacology. ; 2019:3-10. doi:10.1007/164_2019_271
Persaud R, Garas G, Silva S, Stamatoglou C, Chatrath P, Patel K. An evidence-based review of botulinum toxin (Botox) applications in non-cosmetic head and neck conditions. JRSM Short Reports. 2013;4(2):1-9. doi:https://doi.org/10.1177/2042533312472115
Related Articles
Joanna Carr
Hyacorp Filler Pricing: Dispelling Common Myths and Misconceptions
Learn the truth about Hyacorp filler pricing. Doctor Medica dispels myths and misconceptions for informed decision-making.
Joanna Carr
Saxenda Liraglutide – About the Active Ingredient
Liraglutide is the active ingredient in Saxenda, a medication used for weight loss.
Joanna Carr
A Complete Guide to Belotero Under Eyes Treatment
Learn about the benefits, procedure details, potential side effects, and why Belotero is a preferred choice for addressing under-eye concerns. Know mo...

